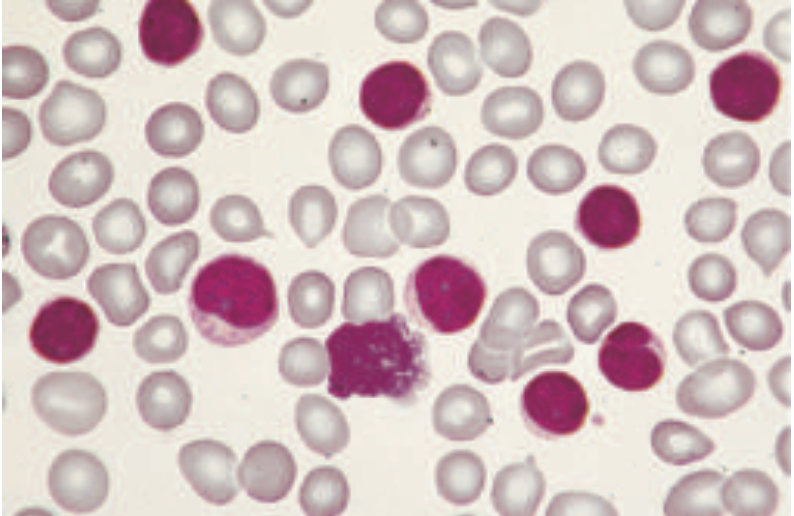

만성 림프구성 백혈병 (CLL)
만성 림프구성 백혈병 (CLL)
정의: 혈액 내 성숙 B 림프구의 단클론성 증식 (절대 림프구 수 > 5,000/μL, 클론성 B세포 ≥ 5 x 10⁹/L)
**CLL vs SLL : 기본적으로 동일한 질병이나, 발현 위치에 따라 구분
CLL (만성 림프구성 백혈병): 암세포가 주로 혈액, 골수에 존재
SLL (소림프구 림프종): 암세포가 주로 림프절, 비장에 존재
임상 양상
대부분 무증상, 우연히 발견
증상 시: 피로, B증상, 림프절 종대, 간/비장 비대
주요 합병증: 감염 (가장 흔한 사망 원인), 자가면역 혈구감소증 (AIHA, ITP), 2차암, 리히터 변환 (DLBCL로의 변환)
검사 및 진단
혈액검사
CBC: 림프구수 증가 (PB B cell ≥ 5,000/μL)
PBS: 작고 성숙한 림프구 증가, 도말세포(Smudge cell) 관찰→ 특징적 소견
유세포분석 (Flow cytometry): 필수검사. 림프구의 클론성 확인, 특이 면역표현형 확인
CD5+, CD19+, CD20+(dim), CD23+
조직검사: 골수생검 (골수침범정도 확인), SLL의 경우 림프절 절제 생검 필수
유전/염색체 검사 (Genetics/FISH): 예후예측 및 치료 방침 결정에 필수
IGHV 변이 상태: 가장 중요한 예후 인자 중 하나
변이형 (Mutated, ≥2% from germline): 비교적 예후 양호 (약 60% 환자)
미변이형 (Unmutated, <2% from germline): 빠른 질병 진행, 불량한 예후와 연관 (약 40% 환자)
FISH: del(17p) 또는 TP53 돌연변이가 최악의 예후
병기 설정 (Rai/Binet staging)
예후 scoring
치료
Low risk (Stage 0): Watch and wait 전략. 초기, 무증상 환자는 즉각적인 치료 불필요
치료 시작 기준 (iwCLL 가이드라인)
진행성 골수 부전: Hb < 10 g/dL, PLT < 100,000/μL, 자가면역 빈혈/혈소판감소증
거대 장기비대: 비장 > 6cm, 림프절 > 10cm
빠른 림프구 증가: 6개월 내 림프구 배가 or 2개월 이내 50% 증가
전신 증상 (B증상): 6개월 이내 체중 10%이상 감소, 심한 피로, 2주이상의 발열, 1달 이상의 야간발한
주요 치료법: 표적치료가 현재 표준
BTK 억제제 (지속 투여): 아칼라브루티닙, 자누브루티닙 (2세대, 선호됨), 이브루티닙 (1세대)
BCL2 억제제 (1년 고정 기간): 베네토클락스 + 오비누투주맙
IGHV변이형 보유 젊은 환자: 항암화학면역요법(FCR = Fludarabin ±Cyclophosphamide ±Rituximab)
재발/불응성 치료:
이전 치료에 따라 BTK 억제제 또는 BCL2 억제제 교차 투여
BTKi 내성 시 (C481S 돌연변이): 피르토브루티닙 (비공유결합 BTKi)
다중 불응성: CD19 CAR-T 세포 치료 고려
[1] Harrison 22e, pg. 849-856
연습문제 10문제
0/10 완료
0개의 글
** 제목만 보더라도 어떤 내용인지 알 수 있도록 완성된 문장으로 작성해주세요.
예시) 초음파 (X) → 초음파 사진에서 PDA 소견을 어떻게 알 수 있나요? (O)